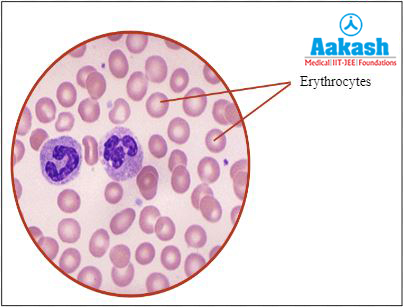
RBCs

-
Call Now
1800-102-2727
Platelets: Thrombopoeisis, Shape and Size, Mechanism of Blood Clotting, Normal Counts, Disorders, Symptoms, Diagnosis, Treatments, Practice Problems, and FAQs
We all like to play on the ground. Sometimes we may get hurt while playing and the blood starts coming out. But you might have noticed that this leaking of blood stops within seconds. You know that this happened due to blood clotting. But have you ever wondered what is the mechanism behind this blood clot or which component of blood is responsible for this phenomenon?
Blood circulates throughout our body and it carries nutrients, gases, secretory and excretory materials along with it to the assigned locations of the body. Blood and lymph are the fluid connective tissues in our body and the only connective tissues that lack any libre. Hence these are called fibreless connective tissues.

GIF: Transport of substances in the blood vessel
We know that blood is composed of 55% plasma and 45% formed elements. The formed elements are of three different types such as RBCs, WBCs and platelets. All the components of the blood have their own specific functions, like the plasma is responsible for transport of substances, RBCs are responsible for transporting respiratory gases, WBCs are the soldiers of the body and protect us from foreign disease causing pathogens. Similarly, platelets have their own important functions. This helps in the formation of blood clots that prevents excessive loss of blood from the body in cases of an injury or accident. Now let’s dive deep and understand more about platelets in this article.
Table of contents
- Blood composition
- Components of blood and their functions
- Thrombopoiesis
- Shape and size of platelets
- Normal platelet counts
- Functions of platelets
- Mechanism of blood clotting
- Diagnosis of abnormal platelet counts
- Platelet disorders
- Practice Problems
- FAQs
Blood composition
Blood is a specialised fluid connective tissue. It lacks fibres, and is composed of two components such as 55% fluid matrix (plasma) and 45% formed elements (RBCs, WBCs and platelets).

Fig: Composition of blood
Components of blood and their functions
The following table shows various components of blood and their functions:
|
Components of blood |
Functions |
|
Plasma
Fig: Plasma |
|
|
Platelets or thrombocytes
Fig: Thrombocytes |
It help in blood clotting |
|
WBCs (White blood cells) or leucocytes
Fig: leucocytes |
It is responsible for providing immunity by fighting against disease causing pathogens that enter the body |
|
RBCs (Red blood cells) or erythrocytes
Fig: RBCs |
It helps in the transport of respiratory gases like O2 and CO2 |
Thrombopoiesis
It is the formation of platelets. Platelets are also called thrombocytes. They are produced in the bone marrow along with all the other blood cells. Bone marrow has stem cells that develop into megakaryoblast under the influence of thrombopoietin. These then develop into huge cells called megakaryocytes. These huge cells break and split into 2000 to 3000 fragments. These fragments are called platelets or thrombocytes and the process is called thrombopoiesis.

Fig: Thrombopoiesis
Shape and size of platelets
Platelets are fragments enclosed in plasma membranes. They contain many vesicles but no nucleus. Each platelet is disc-shaped, and 2 - 4 µm in diameter.

Fig: Thrombocyte
Normal platelet counts
An average healthy adult has 150,000 to 450,000 platelets per µL of blood. Any number higher or lower than this range is considered abnormal.
Functions of platelets
Whenever we get injured and suffer blood loss, it does not happen for very long. This is because the platelets in the blood circulation are responsible for formation of a clot and prevent the loss of excess blood from the body. So, the platelets are required for blood coagulation, which is a homeostatic mechanism of the body to prevent excessive loss of the body fluid.
Mechanism of blood clotting
When we get an injury, the following changes takes place at that site:
- Constriction of the blood vessels.
- Release of clotting factors.
- Formation of thrombin.
- Conversion of fibrinogen into fibrin.
- Formation of a blood clot.
Constriction of the blood vessels
Vascular spasms occur when there is damage or injury to the blood vessels. This results in vasoconstriction, which eventually stops the blood flow. The exposed collagen fibres will release ATP and other inflammatory mediators to recruit macrophages at the injured site in this first phase of blood clotting.
Release of clotting factors
At the site of injury the blood platelets disintegrate and release platelet factor-3 or platelet thromboplastin. Injured tissue also releases a lipoprotein factor called thromboplastin. These two factors combine with calcium ions (Ca2+) and certain proteins of blood plasma to form an enzyme called prothrombinase. This initiates a cascade of reactions where clotting factors are activated one after the other.

Fig: Cascade of reactions for blood coagulation
Formation of thrombin
In the presence of calcium, the prothrombinase inactivates heparin. Prothrombinase catalyses the conversion of prothrombin into an active protein called thrombin and some peptide fragments.
Conversion of fibrinogen into fibrin
Active thrombin acts as an enzyme and converts inactive, globular, soluble fibrinogen into active, thread-like, insoluble fibrin now.

Fig: Conversion of fibrinogen to fibrin
Formation of a blood clot
The fibrin threads form a meshwork on the wound now that seals the wound and prevents exit of blood cells and fluid matrix.

Fig: A blood clot
A dark red to brown colored clot is formed at the site of injury. As the clot retracts, the damaged edges of the blood vessels are pulled together to further reduce the blood loss. Final repair is done by the new endothelial cells in that area. Heparin is activated after repair of the blood vessel.

Fig: A blood vessel with sealed wounds
Diagnosis of abnormal platelet counts
The following tests can be done to determine the platelet counts in the blood:
Complete blood count (CBC)
CBC is a set of medical laboratory tests which provide information about the cells in the person's blood. It indicates the counts of red blood cells, white blood cells, and platelets. It also indicates the concentration of haemoglobin, and the hematocrit.

Fig: Complete blood count (CBC)
Bone marrow test
It is performed in a hospital under the guidance of a doctor. This test involves two steps as follows:
Bone marrow aspiration
This involves the removal of a liquid marrow sample for analysis.
Bone marrow biopsy
This involves the removal of a small amount of bone filled with marrow for analysis.

Fig: Bone marrow aspiration and biopsy
Blood smear test
This is a peripheral blood film prepared on a glass slide that allows the various blood cells to be examined microscopically.

Fig: Blood smear test
Genetic testing
It is a type of medical test done using blood samples to identify the changes in genes, chromosomes, or proteins. This is done in cases of suspected genetic conditions or to help determine the chances of developing or passing on a genetic disorder.

Fig: Genetic testing
Platelets disorders
A normal platelet count in adults ranges from 150,000 to 450,000 platelets per microliter of blood. Any count higher or lower than the normal range of platelets is said to be abnormal and can cause various problems as follows:

Fig: Platelet disorders
High platelet counts
High thrombocyte count may result in thrombocythemia and thrombocytosis.
Thrombocythemia
It is the condition where the platelet count rises but not due to any underlying health condition. It rises because of mutation in genes. This condition is called primary or essential thrombocythemia also. This condition is inheritable, which means it can be passed on from parents to their children.
Thrombocytosis
The condition when the platelet count rises above 450,000 due to some underlying condition like infection, cancer, removal of spleen or anaemia is called thrombocytosis or secondary or reactive thrombocytosis.

Fig: Causes of high platelet counts
Common symptoms of high platelet counts
The following are the common symptoms of high platelet counts:
- Embolism (blocked artery due to clot formation) in brain, hands and feet.
- Dizziness
- Fatigue
- Headache or migraines.
- Numbness in hands and feet.
- Blood in the faeces.
- Nose bleeds.
- Visual impairments.

Fig: Common symptoms of high platelet counts
Treatments of high platelet counts
Patients with thrombocythemia but have no symptoms usually do not require any treatment, whereas, thrombocytosis is treated based on its cause. But, there are certain medications that can be used generally for lowering the platelet counts. Some of them are mentioned below:
- Aspirin - It reduces blood clot formation.
- Hydroxyurea - This medicine is used to treat cancer and sickle cell anaemia as it lowers the platelet count.
- Anagrelide - It is used when hydroxyurea does not work. But it has side effects like irregular heart beats, fluid retention, heart failures and headaches.
- Interferon alpha - It can lower the platelet count but also has serious side effects like nausea, loss of appetite, diarrhoea, sleepiness and irritability.
- Cytotoxic agent - Drugs used to treat high platelet count include cytotoxic agents like hydroxycarbamide.
- Aminocaproic acid - It is an antifibrinolytic agent which is used to treat serious bleeding conditions.
- Hematopoietic stem cell transplantation - It involves the administration of healthy hematopoietic stem cells to patients with depleted or dysfunctional bone marrow.

Fig: Methods to treat high platelet counts
Low Count
Low thrombocyte count may result in thrombocytopenia and haemophilia.
Thrombocytopenia
A low platelets count of less than 150000 is called thrombocytopenia. It can occur due to viral diseases (HIV or hepatitis), aplastic anaemia, lupus, chemotherapy, liver cirrhosis, bone marrow destruction, increased platelet destruction etc.
Haemophilia
It is an inherited clotting disorder caused due to absence of certain clotting factors. It can be characterised by spontaneous intramuscular or subcutaneous haemorrhage, blood in urine and nose bleeds.

Fig: Blood clotting under normal and haemophilic conditions
Common symptoms of low platelet counts
The following are the common symptoms of low platelet counts:
- Easy bruising.
- Prolonged bleeding from injuries.
- Enlarged spleen.
- Heavy menstrual bleeding.
- Bleeding from gums and nose.
- Petechial rash (pinpoint red dots appear on the skin due to broken capillaries or tiny blood vessels under the skin).
- Nausea and drowsiness.

Fig: Common symptoms of low platelet counts
Methods to treat low platelet counts
The following are the methods used to treat low platelet counts:
- Glucocorticoids and intravenous immunoglobulins prevent platelet destruction.
- Immunosuppressive drugs like cyclosporine and azathioprine activate platelets.
- Blood transfusion may also be needed in severe cases.
- Splenectomy - It is the surgical removal of the spleen. This is done as the spleen is the primary site of platelet clearance and autoantibody production.
- Intravenous immunoglobulins - This treatment is used for patients with antibody deficiencies. This temporarily increases the platelet counts.
- Rituximab injections - This raises the platelet counts.
- Anti-D immunoglobulin is used for rapidly increasing the platelet counts in patients.

Fig: Methods to treat low platelet counts
Practice Problems
Q1: Which of the following vitamins is known as a clotting vitamin?
a. Vitamin K
b. Vitamin A
c. Vitamin B12
d. Vitamin C
Solution: Vitamin K or phylloquinone is required for synthesis of prothrombin, an inactive form of a clotting protein. Thereby, it is called the clotting vitamin. Hence, the correct option is a.

Fig: Phylloquinone
Q2: Reduction in the count of which blood cell leads to clotting disorders?
a. Erythrocytes
b. Lymphocytes
c. Thrombocytes
d. Monocytes
Solution: Platelets or thrombocytes are the second most abundant formed elements in the blood after RBCs or erythrocytes. These cells are crucial for coagulation of blood upon injury to prevent excessive blood loss. Thus, a reduction in the number of platelets leads to delayed clotting and loss of body fluids. Hence, the correct option is c.

Fig: Thrombocytes
Q3: Which of the following components in blood prevent the blood from clotting inside blood vessels?
a. EDTA
b. Heparin
c. Histamin
d. Serotonin
Solution: The monocytes in the blood release three factors such as histamine, heparin and serotonin. Histamine is a vasodilator and is responsible for inflammatory reactions. Serotonin is an antagonist of histamine and a potent vasoconstrictor. Heparin is an anticoagulant present in the blood that prevents formation of blood clots inside the blood vessels. EDTA (ethylene diamine tetra acetic acid) is an anticoagulant that prevents blood clotting when blood is taken outside the body in test tubes or in blood bags to keep in blood banks. Hence, the correct option is b.
Q4: Platelets are formed from ________________.
a. Megakaryoblast
b. Macrokaryoblast
c. Macrophage
d. Megakaryocyte
Solution: Platelets are cell fragments of megakaryocytes, produced in the bone marrow. Bone marrow has stem cells that develop into megakaryoblast under the influence of thrombopoietin. These then develop into huge cells called megakaryocytes. These huge cells break and split into 2000 to 3000 fragments. These fragments are called platelets or thrombocytes and the process is called thrombopoiesis. Hence, the correct option is d.

Fig: Thrombopoiesis
FAQs
Q1: What are the different clotting factors?
Answer: There are 13 clotting factors responsible for blood coagulation. The factors and their names are given in the following table:
|
Clotting factors |
Name of the clotting factor |
|
I |
Fibrinogen |
|
II |
Prothrombin |
|
III |
Thromboplastin |
|
IV |
Calcium ion (only non-protein clotting factor) |
|
V |
Proaccelerin (labile factor) |
|
VI |
Presence not proved |
|
VII |
Proconvertin (Stable factor) |
|
VIII |
Anti- haemophilic factor A (AHA) |
|
IX |
Anti- haemophilic factor B (AHB) or Christmas factor |
|
X |
Stuart prower factor |
|
XI |
Anti- haemophilic factor C (AHC) or plasma thromboplastin antecedent (PTA) |
|
XII |
Hageman factor |
|
XIII |
Fibrin stabilising factor (FSF) |
Q2: How is plasma different from serum?
Answer: Plasma contains clotting factors, whereas, serum lacks clotting factors. Thus, plasma can clot but serum does not clot.
Q3: Which is the most common clotting disorder?
Answer: Haemophilia A is the most common clotting disorder. It is caused by a mutation in the gene responsible for synthesis of clotting factor IX or anti-haemophilic factor A or Christmas factor.

Fig: Clotting under normal and haemophilic conditions
Q4: What is the normal count of blood cells?
Answer: The count of various blood cells in a normal healthy adult is as follows:
- RBCs - 4.5 to 5.5 million per µL of blood.
- WBCs - 6000 to 8000 per µL of blood.
- Neutrophils: 60 - 65%
- Lymphocytes: 20 - 25%
- Monocytes: 6 - 8%
- Eosinophils: 2 -3%
- Basophils: 0.5 - 1%
- Platelets - 150,000 to 350,000 per µL of blood.
Youtube link: Introduction to Circulatory System - Body Fluids and Circulation Class 11 Biology Concept Explained
Body Fluids and Circulation Class 11 Biology | Blood & Its Components, Blood Coagulation | NEET Prep
Formation of Clot - Body Fluids and Circulation Class 11 Biology Concept Explained | NEET 2024 Exam